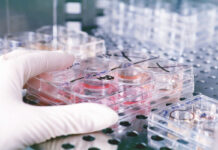
Salmonella Reading in commercial turkeys. Why now and how?
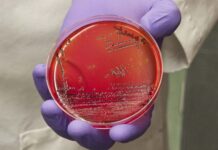
Pathogenesis of egg infections by salmonella – Second Part
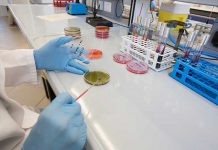
Salmonella prevention strategies and influences of sampling method selection

USPOULTRY Releases Updated Report of Antibiotic Stewardship Within US Poultry Production
Updated research, supported by the U.S. Poultry & Egg Association (USPOULTRY) and the U.S. Food and Drug Administration (FDA), was released today quantifying the...
Animal feed probiotics market expands as antibiotic-free nutrition gains momentum
The global animal feed probiotics market is undergoing a significant transformation as livestock producers increasingly seek sustainable, science-driven alternatives to conventional growth promoters. Valued...
A synergistic herbal alternative combination: curcumshield vs poultry infections – a broad-spectrum study
Introduction
In the case of bacterial infections, various categories of antibiotics – especially synthetic ones – are widely used as broad-spectrum bacteriostatic and bactericidal agents....
Feeding the commercial turkey
Choosing the most effective feeding programme has never been more important given the unpredictability of the raw material market and lack of consistent supply...
NWO OTP grant awarded to WUR project aimed at head start for day-old chicks
The immune system of a chicken starts in the egg. Validated tools to assess how incubation conditions influence immune development are lacking. A new...
Water disinfection in poultry farms: a low-cost practice with high impact
Water is often overlooked as a source of disease risk in poultry farming. Yet, when it comes to biosecurity, drinking water is one of...
The manureshed concept: a solution to poultry litter nutrient recycling?
Surface waters in the United States are regularly assessed as a part of the Clean Water Act to determine whether the water quality protects...
Infectious Laryngotracheitis (ILT) Advisory – City of Kingston
The Feather Board Command Centre (FBCC) is issuing an Infectious Laryngotracheitis (ILT) biosecurity advisory for an approximate 10 km area in the City of Kingston.
FBCC...
Better for birds, the earth, and you: Kipster’s egg
In the United States, as of March 2024, 40% of eggs produced are cage-free. While the cage-free movement has gained momentum worldwide, one company...
Incorporating an essential oil and saponin blend as part of an effective coccidiosis management...
Coccidiosis continues to be a top challenge in the poultry industry and growing evidence of reduced sensitivity to traditional anticoccidials like ionophores and chemicals...
Concurrent infection of Histomonas meleagridis and Eimeria meleagridis in a turkey flock
Blackhead disease (histomoniasis) in turkeys is one of the protozoan diseases sporadically documented in commercial turkey production facilities. Histomoniasis may induce mild, moderate, or...
Clinical coccidiosis in broilers with concurrent infection of Eimeria maxima and Eimeria praecox
Coccidiosis is a complex disease in chickens caused by protozoan parasites in the genus Eimeria. As Eimeria species are ubiquitous in poultry facilities, coccidiosis...
Pathological manifestations of highly pathogenic and predominant Eimeria species in turkeys
Coccidiosis is caused by intra-cellular enteric protozoan parasites of the genus Eimeria. Eimeria is a gastrointestinal parasite with a complex life cycle involving an...
Cecal coccidiosis in turkeys
Cecal coccidiosis is an important disease that affects the cecal integrity of turkeys and may result in watery feces with flecks of blood. In...
Poultry gut health critical to NAE production
The production of “No Antibiotics Ever” (NAE) poultry is a common trend worldwide today. Despite scientific evidence indicating that specific antibiotic growth promoters (AGP)...
Overcoming challenges of antibiotic-free production
Antibiotic use once became a conventional, on-farm practice to prevent health issues and boost growth in poultry. Yet, public health concerns about rising bacteria...
When the gut rebels: the challenge of chronic inflammation in laying hens
In the poultry industry, intestinal health is a cornerstone for achieving high production yields, feed efficiency, and disease resistance. One of the issues that...
Biosecurity, before the beginning…
Almost all of us, the poultry people, know what biosecurity is about. For the investors, it means spending lots of money to prevent disasters,...
Case report: histomoniasis in broiler breeder pullets
Histomoniasis, commonly known as blackhead disease, is caused by an anerobic protozoan parasite, Histomonas meleagridis. Histomoniasis affects all gallinaceous birds and turkeys are the...
Histopathological evaluation of Histomonas meleagridis on ceca and the bursa of Fabricius in turkeys
Histomoniasis is caused by Histomonas meleagridis, a flagellated protozoan parasite. It causes systemic infection in turkeys and induces characteristic lesions in ceca and liver....
Detection of antibodies against Chlamydia species in chicken serum
Avian chlamydiosis is a bacterial infection caused by Chlamydia bacteria. The currently available tests distinguish Chlamydia species based on genetic material. Researchers from Wageningen...
Biological control of Salmonella in the poultry industry: a European perspective
Salmonella remains one of the most important foodborne bacterial pathogens worldwide, and is frequently linked with the consumption of contaminated poultry meat and eggs....
Detection and quantification of Gallibacterium anatis and Mycoplasma synoviae
Mycoplasma synoviae is one of the most common preconditions for secondary bacterial infections in poultry. It causes subclinical infections of the upper respiratory tract,...
The ABCs of CDT (Clostridial Dermatitis of Turkeys)
Clostridial Dermatitis of Turkeys (CDT), also referred to as Cellulitis, remains a major disease issue across all geographic regions of the US; the annual...
Targeted preharvest interventions against Salmonella in turkeys
Salmonella is a foodborne zoonotic pathogen prevalent in poultry production, including turkeys. The pathogen is a constant threat to human public health because of...
Researchers investigate the characteristics of Turkey Hepatitis Reovirus
USPOULTRY and the USPOULTRY Foundation announced the completion of a funded research project at the University of Minnesota in which researchers investigated the characteristics of Turkey...
Turkey dermatitis/cellulitis: where are we headed?
Clostridium septicum is a ubiquitous, spore-forming bacterium associated with spontaneous gas gangrene in both livestock and humans. The spores can persist in harsh environments,...
Use of comparative genomics to identify vaccine candidates for Campylobacter Jejuni
Interventions to control and reduce the incidence of Campylobacter jejuni colonization in poultry is important in order to reduce the burden of foodborne illness in humans....
Researchers investigate the cause and prevention of False Layer Syndrome
USPOULTRY and the USPOULTRY Foundation announced the completion of a funded research project at the University of Georgia in which researchers investigated the cause and prevention...
How Marek’s disease may directly affect the chicken immune system
Marek’s disease virus (MDV) causes disease in chickens and is estimated to cost the global poultry industry up to US $2 billion each year.
In...
Obtaining the most benefit from an anticoccidial sensitivity test
The poultry industry has been using the same anticoccidial drugs for the prevention of coccidiosis for several decades. The last approval of a new...
Salmonella Reading in commercial turkeys. Why now and how?
Salmonella sp. is one of the most common bacteria associated with foodborne illness in humans. Each year in the United States, foodborne salmonellosis causes...
Optimizing immunization through proper vaccination in turkeys
When we talk about optimizing immunization through proper vaccination in commercial turkeys, we are really talking about optimizing drinking water vaccination when we think...
Pulsed ultraviolet light processing of eggs
In recent years, pulsed ultraviolet light has been shown to reduce microbial pathogens on the surface of shell eggs, crucial for maintaining good chick...
Gut health in poultry production: why, what and how
Gut health has become a dominant topic in the global poultry industry. But why did the topic emerge to become so important to the...
Profiling Salmonella serotypes through broiler processing
USPOULTRY and the USPOULTRY Foundation announce the completion of a funded research project at the University of Georgia in which researchers profiled Salmonella serotypes through broiler processing.
The...
Cochlosoma anatis in turkeys
A funded research project at North Carolina State University in Raleigh, N.C. evaluated the pathogenicity of Cochlosoma anatis. The research was made possible in...
Enumeration of Ascaridia Galli eggs in chicken excreta
Excreta counting techniques in eggs can provide valuable information for assessing flock infection levels, selecting nematode resistant chicken breeds and for determining anthelmintic efficacy.
Although...
Pirbright’s new Avian Influenza vaccine
An improved poultry influenza vaccine has been developed by researchers from The Pirbright Institute. The potential vaccine triggers a rapid immune response which protects...
Protozoal management in turkeys
The two turkey protozoa that cause significant animal welfare and economic distress include various Eimeria species of coccidia and Histomonas meleagridis. For coccidia, oral...
Increased cecal butyrate concentrations protect against Salmonella Enteritidis
Butyrate is a molecule that is extensively studied as a feed additive to improve gut health and animal performance. It also has been described...
A review of novel biological alternatives to antibiotic therapies in poultry
As poultry producers in Australia continue to limit antibiotic use, increasing numbers of alternative therapies and chemical biosecurity products are being used to overcome...
Key global health issues in cage-free and organic laying hens
In USA and Europe there has been a growth in cage-free, free range, and organic production over the last 10 years.
The percentage of all...
Coccidiosis control in broiler breeders with the use of vaccines by Aviagen®
Coccidiosis is a disease of the intestinal lining, produced by the invasion of the mucosal cells by a very prolific protozoan parasite of the...
Infectious Coryza in vaccinated layers: are vaccines failing to protect?
During 2017 and 2018 Infectious Coryza was detected in several commercial vaccinated egg layer flocks in California. The Avibacterium paragallinarum strains isolated from infected...
How to guard your hatchery against biosecurity threats
Biosecurity, by simple definition, is a set of procedures undertaken to limit the spread of infectious pathogens to a susceptible population. It is, however,...
In-ovo corticosterone alters body composition in 35 day old chi-cken meat birds
Increasing evidence suggests early-life exposure to maternal stress can permanently alter thedevelopment of an embryo. Such findings have significant application to the chicken meat...
Pathogenesis of egg infections by salmonella – Second Part
Early protection has been demonstrated after primary live vaccine administration early post-hatch but this effect is serotype-specific, while cross-protection between some serotypes has been...
Interrupting cholesterol pathway reduces Marek’s disease spread
In a new discovery, scientists from The Pirbright Institute confirm that cholesterol production and transport play a crucial role in how Marek’s disease virus...
Turkey arthritis reovirus. Diagnostic strategies
Avian reoviruses (ARVs). They are non-enveloped viruses of 70-80 nm size having an icosahedral symmetry. The viral genome has 10 segments of double stranded...
Mycoplasma Synoviae, a technical update
Mycoplasma are the smallest free-living organisms both in size and number of genes, and unlike many other bacteria, they do not have a cell...
Adaptability of bird flu poses threat to poultry
New insights from a study of the 2016/17 bird flu outbreak show how highly pathogenic bird flu viruses – which are likely to cause...
Researchers characterize selected variant Avian Reovirus strains
USPOULTRY and the USPOULTRY Foundation announce the completion of a funded research project at the University of California, Davis, in which researchers looked to...
Avian reovirus, molecular characterization
Avian reovirus (ARV) is the main cause of viral arthritis and tenosynovitis in chickens and turkeys, triggering economic losses in the poultry industry due...
Role of dietary calcium in Necrotic Enteritis development and pathogenesis
USPOULTRY and the USPOULTRY Foundation announce the completion of a funded research project at Texas A&M University in College Station, Texas, in which the...
Pathogenesis of egg infections by Salmonella – First Part
Salmonella is an invasive bacterial genus and colonizes the gut of chickens, and systemically spreads to internal organs, including the reproductive tract, potentially leading...
The effects of diet and epigenetic alterations on the gut microbiome, inflammation and poultry...
The gut microbiota is a fundamental force influencing diverse aspects of avian physiology. Microbiome studies are at a critical juncture and facing a challenging...
Infectious bronchitis virus shuts down cell stress signals
A new study from scientists at The Pirbright Institute and collaborators at the University of Surrey provides evidence that infectious bronchitis virus (IBV) can regulate the...
Towards practical methods for assessing ILTV vaccine take
In response to ILTV outbreaks, live vaccines are typically administered at 7-14 days of age in drinking water via nipple drinkers which may not...
Researchers examine the role of APEC in turkey cellulitis
USPOULTRY and the USPOULTRY Foundation announce the completion of a funded research project at the University of Georgia in Athens, Georgia, in which researchers...
Infectious bursal disease viruses may swap genetic material during infection
Live cell imaging has been used by researchers at The Pirbright Institute to reveal new information about how different strains of infectious bursal disease virus...
Chicken study probes resistance to food bug
Receiving gut microbes from resistant chickens does not lessen chickens’ susceptibility to bacterium that causes food poisoning.
Susceptible chickens became even more susceptible to Campylobacter,...
Research examines novel next generation sequencing techniques
USPOULTRY and the USPOULTRY Foundation announce the completion of a funded research project at the University of Georgia in Athens, Georgia, in which researchers...
Influenza antibodies made by Pirbright reduce disease in chickens
Scientists at The Pirbright Institute have engineered synthetic antibody
molecules that can be administered to poultry to reduce the symptoms of Influenza, as well as...
Prevention and control of biofilm in water line systems as part of biosecurity protocols
This paper does not address
the situations in which the microbiological quality of the water
has been compromised from the beginning; rather, this paper addresses how
drinking...
Footpad dermatitis in market turkey hens. Bird density and bedding material relationships
Lameness
and poor footpad condition can be major issues for meat-type poultry resulting
in their decreased well-being and decreased productivity. A large body of
research exists for...
Get the most from your diagnostic laboratory.
A field perspective.
You notice the
mortality is up this morning in one of your brooder houses. Your first thought
might be “better take some birds to...
Salmonella prevention strategies and influences of sampling method selection
Multiple factors can influence both Salmonella prevalence and diversity of Salmonella serogroups detected from both pre and post-harvest samples. Sampling methodologies vary widely when...
Pirbright’s livestock coronavirus research
The Pirbright Institute is aware that misinformation regarding the Institute and its research is circulating on social media following an outbreak of a new...
Pulmonary Nocardiosis in turkey poults
Nocardiosis is an opportunistic, noncontagious, pyogranulomatous or suppurative disease of domestic animals, wildlife and people. In domestic animals, it causes mastitis, pneumonia (granulomatous lesions...
How do coccidiosis challenges influence lipid digestibility and energy utilisation?
Coccidiosis continues to be one of the most pervasive and economically detrimental diseases in commercial poultry production. Controlling this enteric disease is an even...
The importance of gut microbiota in chickens
Recent expansion in knowledge about the influence of microbiota on health and disease started a major research revolution in the area. Intestinal systems of...
Sample management and handling for diagnostic testing
Diagnostic testing is an important and widely used tool in commercial poultry husbandry. A key to best use of diagnostic testing, is to begin...
Protecting poultry from Avian Influenza
The Avian Influenza season is upon us, but how much do you know about Avian Influenza? Do you know how to protect the birds...
Host and microbial biomarkers for intestinal health and disease in broilers
New tools can be used to determine the gut health status of animals and to predict animal performance or to make a decision whether...
Chlamydia spp. detected in poultry in Piedmont, Italy
Chlamydia spp. are agents of re-emerging infections in poultry worldwide and deserve attention from a public health perspective due to the well-known zoonotic nature...
A diagnostic laboratory perspective for pathogen detection
Detection of infectious diseases can generally be broken down into laboratory detection of the pathogen or detection of the immune response to the pathogen....
Research provides Insight on colonization of broilers by Salmonella
USPOULTRY and the USPOULTRY Foundation announce the completion of a funded research project at Auburn University in Auburn, Alabama, in which researchers were able...
First-Ever Report of antimicrobial ase across U.S. broiler chickens and turkeys
Dramatic antimicrobial usage changes and improved antimicrobial stewardship.
The new report shows dramatic reductions of turkey and broiler chicken antimicrobial use over a five-year timeframe....
A multidisciplinary research approach on Avian Influenza in Italy
The Avian Influenza epidemic of 2016-2017 had been the largest in Europe in more than 10 years. The circulating virus was a Highly Pathogenic...